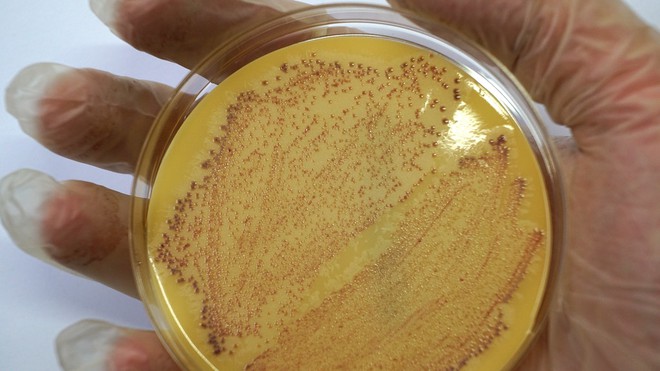
C&ocirc; g&aacute;i 29 tuổi vốn khỏe mạnh tử vong 10 ng&agrave;y sau khi nhiễm si&ecirc;u vi khuẩn đục lỗ phổi - Ảnh 2.

Cô gái 29 tuổi vốn khỏe mạnh tử vong 10 ngày sau khi nhiễm siêu vi khuẩn "đục lỗ phổi"
Một người phụ nữ ở Úc đột ngột qua đời vài ngày sau khi nhiễm siêu vi khuẩn tấn công các cơ quan nội tạng và đục lỗ phổi.
Ashley Timbery, 29 tuổi, ở Úc dường như hoàn toàn khỏe mạnh, ngoại trừ vài vết mụn nhọt chỉ thấy hơi mệt và buồn ngủ trước khi cô ngã gục bên đường. Cô được đưa đến Bệnh viện Memorial quận Shoalhaven, Sydney (Úc) và các bác sĩ đã tìm thấy vi khuẩn trong phổi của cô.
Cô được chuyển đến Bệnh viện St George, nơi cô được chẩn đoán nhiễm Staphylococcus vàng kháng methicillin - còn được gọi là siêu vi khuẩn MRSA. Nó gây ra bệnh viêm phổi và Ashley tử vong 10 ngày sau đó. Anh họ của cô, Shantelle Locke, nói với tờ Yahoo News Australia rằng: "Hóa ra Ashley bị một loại siêu vi khuẩn tấn công tất cả các cơ quan của mình, sau đó bị viêm phổi và cuối cùng nó đã giết chết cô ấy.

Ashley Timbery dường như hoàn toàn khỏe mạnh trước khi mọi chuyện xảy ra
Ashley bị nhiễm trùng huyết khắp cơ thể. Các bác sĩ cho chúng tôi xem ảnh chụp CT cho thấy phổi bình thường. Sau đó, họ cho chúng tôi xem phổi của Asley có rất nhiều lỗ - đây là kết quả của việc phổi bị tắc do viêm phổi và do siêu vi khuẩn bắt đầu cư trú trong các khoang phổi".
Theo Dịch vụ Y tế Quốc gia Anh (NHS), MRSA thường sống vô hại trên da nhưng nếu xâm nhập vào cơ thể, nó có thể gây nhiễm trùng nghiêm trọng cần điều trị ngay bằng kháng sinh. Các triệu chứng của MRSA bao gồm có một vùng da bị đau và sưng tấy, có cảm giác ấm khi chạm vào, rỉ mủ hoặc chất lỏng và có màu đỏ.
MRSA (Ảnh: University of Bath)
Nếu nhiễm trùng lây lan vào máu hoặc phổi, mọi người có thể bị sốt cao, khó thở, ớn lạnh, chóng mặt và lú lẫn. MRSA có thể được điều trị bằng kháng sinh, những trường hợp nhiễm trùng nghiêm trọng hơn có thể cần được điều trị tại bệnh viện bằng kháng sinh tiêm hoặc nhỏ giọt vào tĩnh mạch trên cánh tay của bạn. Bạn có thể cần dùng kháng sinh trong vài ngày hoặc tối đa vài tháng, tùy thuộc vào mức độ nghiêm trọng của nhiễm trùng.
Nếu bạn gặp biến chứng, bạn có thể cần điều trị thêm, chẳng hạn như phẫu thuật để dẫn lưu mủ tích tụ (áp xe). Những người ở nhà chăm sóc và bệnh viện (đặc biệt là những người phải phẫu thuật) có nguy cơ bị nhiễm MRSA cao hơn. Nếu bạn đang đến thăm ai đó tại nhà chăm sóc hoặc bệnh viện, hãy làm theo mọi hướng dẫn như rửa hoặc vệ sinh tay của bạn thật kỹ lượng.
Nguồn và ảnh: The Mirror
